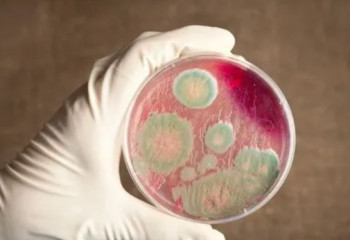
Алматы облысында сібір жарасы көмілімі табылды

25.05.2026
Оқушыларға арналған жазғы жұмыс: кімдер 350 мың теңге таба алады?
25.05.2026
Оқушыларға арналған жазғы жұмыс: кімдер 350 мың теңге таба алады?
22.05.2026
Турист тартамыз деп есекті «зебраға» айналдырғандар жазаға тартыла ма?
30.04.2026
«Таза Қазақстан»: Алматы облысында 5100 түп ағаш көшеті отырғызылды
02.12.2025
Қазақстандық танымал спортшылар жол апатынан қаза тапты
25.11.2025
Амангелді Бектасовты еске алуға арналған турнир: үздіктер анықталды
21.11.2025
Танымал боксшыны еске алуға арналған турнир басталды
08.11.2025
Алматы облысында сібір жарасы көмілімі табылды
18.10.2025
Ат спортынан Қазақстан чемпионаты басталды
16.10.2025
Алматы облысында ат спорты бойынша Қазақстан чемпионаты өтеді
16.10.2025
Қонаевтан Токиоға дейін: қазақстандық хирургтар Жапонияда тағылымдамадан өтеді
11.10.2025
Нұрғиса Тілендиевтің туған ауылында еңселі стела орнатылды
09.10.2025
Үсік, тұман: 9 қазанда ауа райы қандай болады